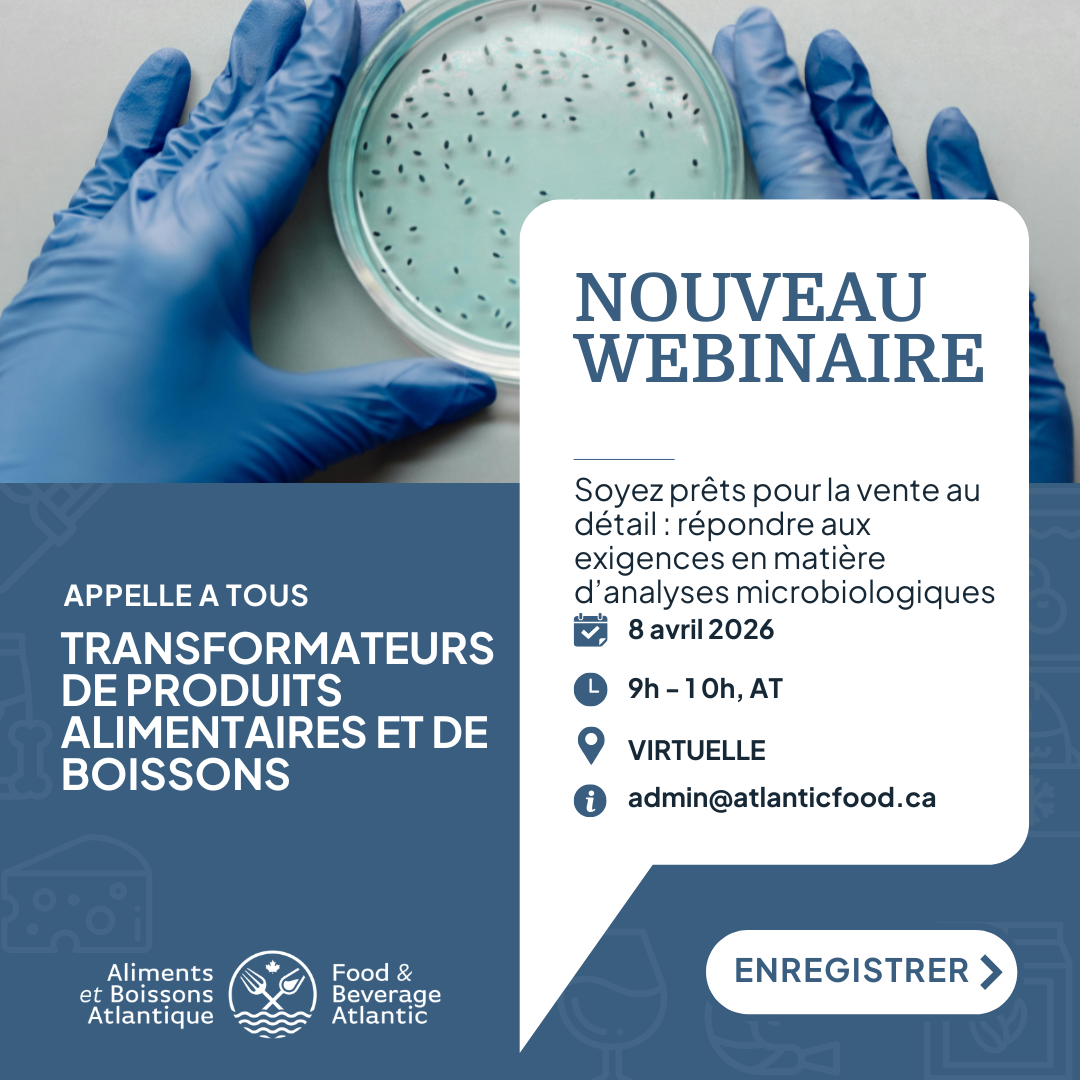

Les détaillants rehaussent leurs attentes en matière de salubrité des aliments, de vérification de l’assainissement et de surveillance de l’environnement. Joignez-vous à Aliments et boissons de l’Atlantique et LuminUltra pour une séance pratique, éclairée par les audits, conçue pour aider les transformateurs alimentaires et de boissons à renforcer leurs programmes de surveillance environnementale et à démontrer leur préparation au commerce de détail en toute confiance.
Prêt pour le commerce de détail : répondre aux attentes en matière d’analyses microbiennes va au-delà des listes de vérification de conformité pour examiner comment les détaillants et les auditeurs évaluent l’efficacité de l’assainissement, le contrôle de l’environnement et la gestion des risques. Cette séance d’une heure met l’accent sur les thèmes d’audit courants, les pratiques exemplaires des fournisseurs et la façon dont des outils de surveillance améliorés peuvent soutenir des programmes de salubrité des aliments plus solides et plus faciles à défendre, sans complexité inutile.
Animée par des professionnels expérimentés de l’industrie de LuminUltra, la séance combine des cas d’utilisation concrets et des conseils pratiques afin d’aider les participants à comprendre non seulement ce que les détaillants attendent, mais aussi comment harmoniser les programmes de surveillance pour répondre à ces attentes de manière significative.
Vous quitterez cette séance avec :
- Une compréhension plus claire de la façon dont la surveillance environnementale soutient la confiance des détaillants et des audits
- Une meilleure compréhension de la manière dont les tests A3 (ATP + ADP + AMP) peuvent offrir une vérification de l’hygiène plus précoce et plus sensible que les approches fondées uniquement sur l’ATP
- Des façons pratiques de combiner la vérification de l’hygiène, la détection rapide des agents pathogènes et les analyses effectuées par des laboratoires accrédités dans un programme de surveillance fondé sur le risque
- Des orientations sur l’utilisation des données de surveillance environnementale pour appuyer les discussions lors des audits et démontrer l’efficacité des programmes
Cette séance est idéale pour les fabricants alimentaires, les co-emballeurs, ainsi que pour les responsables de la qualité, de la salubrité des aliments, de l’assainissement et des opérations qui approvisionnent des clients du commerce de détail ou du secteur des services alimentaires, y compris les petits et moyens transformateurs qui se préparent à desservir de plus grands comptes, ainsi que les fabricants établis qui cherchent à renforcer leur préparation aux audits.
Vos conférenciers pour ce webinaire :
Sarah Cook
Sarah Cook est directrice du développement des marchés, secteur Aliments et boissons, chez LuminUltra, avec 20 ans d’expérience dans des environnements de production alimentaire réglementés. Elle travaille en étroite collaboration avec les transformateurs afin de renforcer les programmes de surveillance environnementale, d’améliorer les stratégies de vérification de l’assainissement et d’accroître la confiance dans la prise de décisions liées aux analyses microbiologiques. Forte d’une expérience en audit, en fabrication d’aliments pour animaux, en transformation des produits de la mer et en gestion des systèmes qualité, Sarah apporte une perspective pratique et ancrée dans l’industrie, axée sur l’accompagnement des équipes au-delà de la conformité vers des programmes de salubrité alimentaire résilients et prêts pour les audits.
Peter Beers
Fort de plus de 15 ans d’expérience dans la fabrication d’aliments et de boissons, Peter Beers est spécialisé en stratégies d’assainissement et en systèmes qualité dans des environnements de production complexes. Il a collaboré avec des transformateurs à travers l’Amérique du Nord afin de moderniser les programmes de surveillance environnementale et de renforcer la conformité aux référentiels d’audit tels que BRC, SQF et l’ACIA. Chez LuminUltra, Peter travaille aux côtés de leaders de l’industrie pour faire progresser les approches de surveillance microbiologique, améliorer la validation des procédures d’assainissement et aider les organisations à bâtir une culture proactive de salubrité alimentaire, fondée sur les données, la responsabilisation et l’amélioration continue.